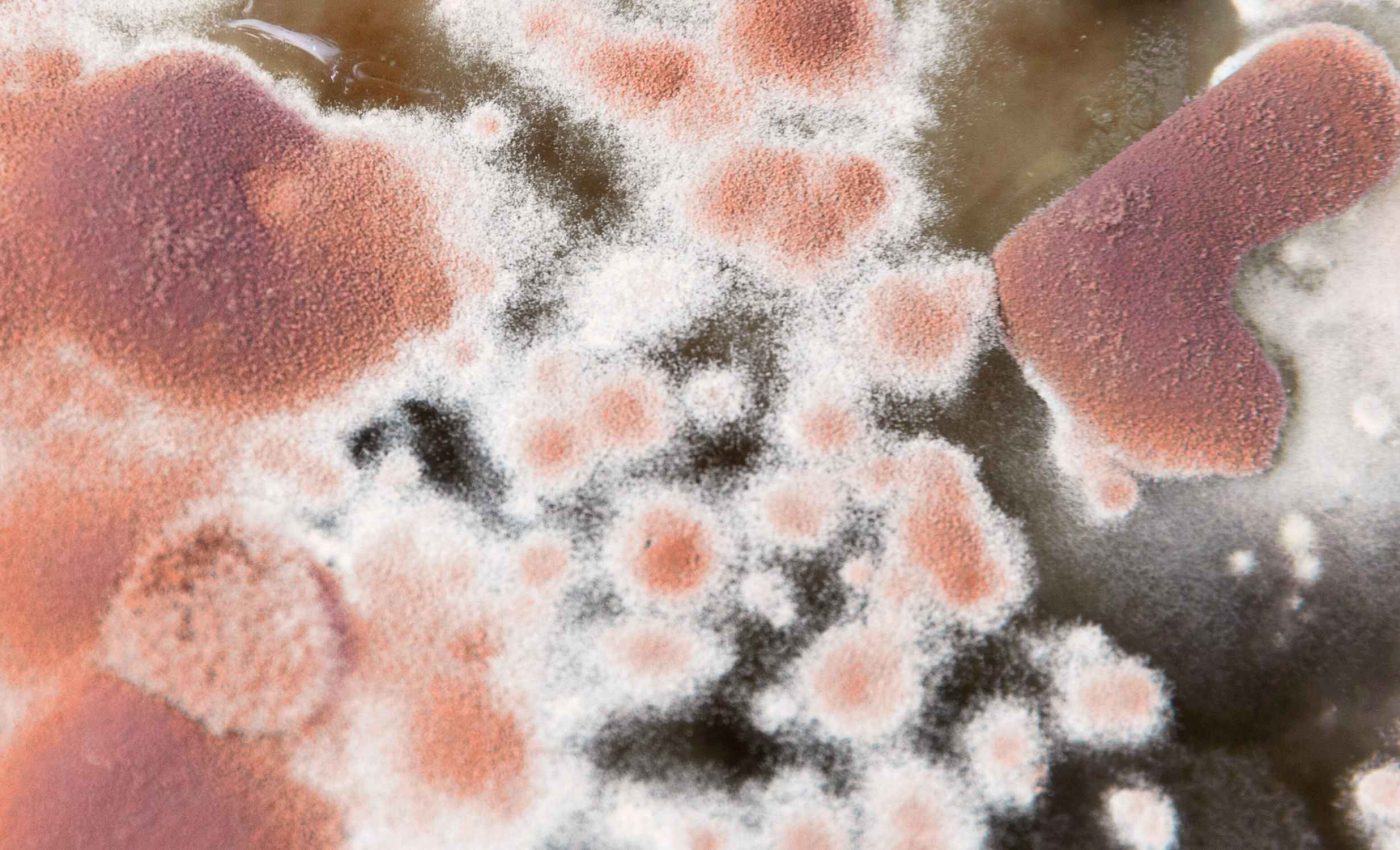
Longest-living fungi are able to slow down deadly mutations for centuries

In forests and fields across the world, some fungi quietly spread across land and live for centuries while their cells keep dividing and repairing damage normally caused by mutations.
New research in the Netherlands suggests that some long-lived mushroom forming species use a genetic checkpoint that blocks harmful mutations.
In some forest fungi, DNA analysis shows that one underground individual fungus starting from a single spore can stretch across hundreds of acres and live for roughly 2,500 years.
These fungi begin their life cycle as a mycelium, which are branching underground network of threads that absorbs nutrients.
Each thread, called a hypha, carries a flowing mix of cytoplasm and tiny nuclei rather than neat, sealed off cells.
The work was led by Duur Aanen, an evolutionary biologist at Wageningen University & Research (WUR) in the Netherlands.
His research focuses on how cooperation and genetic conflict unfold inside fungal networks over very long lifespans.
In many mushroom forming species, each cell in the main body contains two separate nuclei, a state called a dikaryon.
This state lets a fungal cell hold two distinct haploid genomes and lets both nuclear lineages share the same cytoplasm while they divide.
That arrangement creates room for trouble. If a mutation hits one nucleus and helps it reach the spore forming structures, that nucleus can spread while weakening the mycelium.
Mutations like this are selected inside the mycelium but reduce the fitness of the whole network, so they act like selfish teammates.
“You can think of them as a kind of ‘nucleus cancers’,” explained Aanen. Researchers first saw these cheaters in fast growing molds where mutated nuclei lost the ability to fuse with their own filaments.
Those defective nuclei could still exploit nearby cooperative mycelia to gain food and spore forming opportunities.
This problem echoes the behavior of cancer cells in animals. A somatic mutation, a DNA change that appears in body cells, not gametes, can make one cell lineage grow faster while hurting the organism.
Across mammals, cancer risk stays surprisingly similar even as body size and lifespan change a lot. This pattern, known as Peto’s paradox, is the puzzle that big animals are not much more cancer prone.
Large animals appear to solve this puzzle by layering extra safeguards onto their tissues. Elephants, for example, carry extra copies of the tumor suppressor gene TP53 and their cells self-destruct after damage, cutting off tumors early.
Aanen and his colleagues argue that long lived fungi use an unusual tactic. In a recent paper they describe a structure called a clamp connection, which is a hook-like branch that forms on a hypha as it divides.
During each division, one nucleus moves forward into the new tip cell while the other nucleus detours into the clamp.
That clamp then grows backward and must successfully fuse with the cell just behind the tip, restoring the two nucleus state.
“Both nuclei [are] continuously testing each other for the ability to fuse,” said Aanen. If a nucleus fails this fusion test inside the clamp, it ends in a dead end compartment and its lineage disappears from the front.
Over many years, this repeated screening should keep cheater nuclei rare. The team argues that fungi with clamp connections keep their lifetime risk of internal genetic freeloaders low, even in huge and ancient networks.
Short lived molds tackle the same problem in another way. They grow quickly, fragment often, and throw off frequent asexual spores, which act as repeated bottlenecks that purge many harmful mutants before the next generation starts.
The idea that long lived fungi keep a stable internal genome fits with evidence from enormous forest fungi such as Armillaria gallica.
In one such individual, they detected very few new DNA changes across its entire genome, which points to an unusually low mutation rate.
By contrast, some other mushroom forming fungi seem comfortable with far more genetic change.
In the wood decay species Schizophyllum commune, measurements in the lab suggest that mutations stack up quickly as the mycelium extends.
Placing these fungal strategies next to animal examples shows a broader pattern. Evolution keeps finding ways to let many cells cooperate for decades or centuries without being overrun by selfish clones.
The details differ between elephants, whales, and mushrooms, yet all of them rely on internal quality control to stay healthy over long lifespans.
In fungi, clamp connections may be a simple ancient version of this idea, guiding networks to persist while quietly ejecting potential cancers.
The study is published in Microbiology and Molecular Biology Reviews.
—–
Like what you read? Subscribe to our newsletter for engaging articles, exclusive content, and the latest updates.
Check us out on EarthSnap, a free app brought to you by Eric Ralls and Earth.com.
—–
